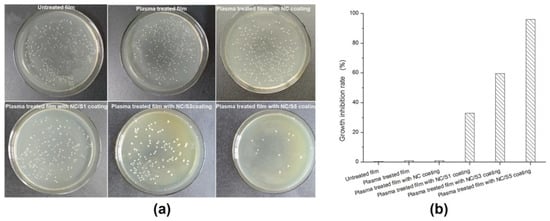

Abstract
The application of nanofibrillated cellulose (NC) films in packaging industry has been hindered by its lack of heat-sealing ability. Incorporation of NC films with the biaxially oriented polypropylene/low density polyethylene (BOPP/LDPE) laminates can take advantage of each material and endow the films with novel functions for food packaging applications. In this study, a coating that consists of NC and nisin was applied onto a cold plasma treated BOPP/LDPE film to fabricate a novel active packaging with an improved oxygen barrier performance and an added antimicrobial effect. The results showed that cold plasma treatment improved the surface hydrophilicity of BOPP/LDPE films for better attachment of the coatings. NC coatings significantly enhanced oxygen barrier property of the BOPP/LDPE film, with an oxygen transmission rate as low as 24.02 cc/m2·day as compared to that of the non-coated one (67.03 cc/m2·day). The addition of nisin in the coating at a concentration of 5 mg/g caused no significant change in barrier properties but imparted the film excellent antimicrobial properties, with a growth inhibition of L. monocytogenes by 94%. All films exhibit satisfying mechanical properties and transparency, and this new film has the potential to be used as antimicrobial and oxygen barrier packaging.
1. Introduction
Nano-fibrillated cellulose (NC) is a novel nanomaterial prepared from natural cellulose fiber. NC has a high aspect ratio (4–20 nm wide, 500–2000 nm in length) and also excellent film forming ability because of physical entanglement and hydrogen bonding between adjacent NC [1]. NC was reported to have prospective applications for bio-based materials to be used in food packaging, for instance, as reinforcement filler and plasticizer in edible films [2], as self-standing thin films for modified atmosphere packaging [3], or as a coating over paper packaging [4,5]. In particular, NC film has a good oxygen barrier property [6] which is important in food packaging considering prevention of lipid oxidation [7]. As a matter of fact, oxygen transmission rates (OTR) values of NC films in dry conditions are competitive with synthetic polymers of approximately same thickness [8]. However, several features of NC films such as high hygroscopicity and lack of heat-sealing ability limit it practical use in food packaging especially compared with conventional plastic films.
Flexible films of polyethylene-based polymer such as low-density polyethylene (LDPE) or high-density polyethylene (HDPE) have varied applications in food packaging industry due to its low cost, good moisture proof, good durability, and processibility. In fact, the oxygen permeability of PE films is relatively high [9] and certain barrier technologies are being developed to provide PE based films a more efficient oxygen barrier performance. A widely used method of creating high oxygen barrier is by laminating or coating a barrier material such as ethylene vinyl alcohol (EVOH), polyvinylidene chloride (PVDC), evaporated aluminum, SiOx [10], fluorocarbon, or zein [11]. In light of high barrier performance of nanocellulose [12], NC films can also be incorporated with PE-based packaging material for different applications in food packaging. There are several promising approaches using nanocellulose for barrier packaging purposes, e.g., layer-by-layer assembly, electrospinning, composite extrusion, casting evaporation, and coating, but the application of NC on PE-based film by means of direct coating is few in reports. In principle, the natural adhesion of NC onto LDPE surface is very poor, because NC are hydrophilic in nature but the surface of LDPE film is hydrophobic with low surface tension. To overcome this problem, cold plasma process can be employed as a pretreatment of LDPE film to generate a hydrophilic surface [13]. Cold plasma treatment performs under atmospheric or low pressure conditions [14,15] and modify the surface properties of LDPE films, such as wettability [13], surface energy and chemical structure [16], enabling and the deposition of thin water-based coatings on the polymer surface and the consequent production of multilayer films [17].
Antimicrobial efficiency is another important concept in food packaging considering the growth control of micro-organisms that cause food-borne illnesses [18]. Bare plastic films do not possess any antimicrobial activity against the growth of microorganisms in the packed food [19], but it can be impart antimicrobial potency through incorporations of organic acids [20], nanoparticles [21], essential oils [22], as well as bacteriocin [23]. Since packaging materials directly contact with food in most cases, use of antimicrobials should be considered carefully and food-grade additives are drawing more attention. Nisin is an antimicrobial peptide generally recognized as safe (GRAS) by the US Food and Drug Administration and commercially used as natural preservative [24]. Nisin has been used for the control of gram-positive pathogens, especially L. monocytogenes, in variety of products such as cheese, meat, and canned foods, either as additives in food directly [25] or incorporation with packaging materials [26,27] by means of extrusion [28], layer-by-layer adsorption [29,30], covalently immobilization [31,32], and surface coating [33]. As micro-organisms grow primarily at the surfaces of the foods in most packaged solid or semi-solid foods, antimicrobial activity should be preferably exerted on the surfaces. Considering of the attractive qualities of NC, it is promising to combine nisin with NC in the manufacture of novel functional packaging materials. Khan et al. suggested that NC film with nisin adsorption can significantly reduce the growth of L. monocytogenes [34]. However, reports about the incorporation of NC and nisin with LDPE and its effects on the packaging materials are rare in current research. In contrast to extruding NC and nisin into the LDPE polymer matrix, surface coating enables a better control of microbes due to direct contact between nisin and packed food. Therefore, in this study for the first time an active coating that consists of nisin and NC was applied onto cold plasma treated biaxially oriented polypropylene (BOPP)/LDPE film to fabricate a new active packaging film.
The objective of this study was to upgrade conventional BOPP/LDPE film for active packaging application with enhance barrier and antimicrobial performances by functional coatings of NC and nisin. Cold plasma treatment of BOPP/LDPE film facilitated the attachment of NC/nisin coating layer in a restricted area and enabled the reservation of heat-sealing merit of the film. The barrier properties of the prepared film as well as its inhibition effect against L. monocytogenes were investigated to evaluate the efficiency of coated BOPP/LDPE as a functional film for active food packaging.
2. Materials and Methods
2.1. Materials
Commercial BOPP/LDPE laminates were supplied by Guangxi Institute of Quality Research, cut to size 120 mm × 160 mm and used as substrates for coating throughout this study. NC suspension at 2.0% by weight of solid contents was produced from cellulose pulp (bleached sulfite softwood pulp) at Guangxi Key Laboratory of Clean Pulp and Papermaking and Pollution Control. Nisin (≥1000 IU/mg) was obtained from Aladdin, Shanghai, China. Other chemical reagents used in this research were all of chemical grade without any purification. All aqueous solutions were prepared using purified water. L. monocytogenes (strains ATCC19115) was obtained from China Center of Industrial Culture Collection (Beijing, China).
2.2. Plasma Treatment
Cold plasma treatment of BOPP/LDPE films was carried out on a dielectric-barrier discharge (DBD) plasma system (XRK4, Nanjing Suman Electronics Co., Ltd., Nanjing, China) prior to the application of the coatings. A schematic representation of the experimental setup is presented in Figure 1a. The film sample was placed between the two plane-parallel metal electrodes with a separation distance of 5 cm. The surface of the LDPE side of the BOPP/LDPE laminates were plasma treated and the size of the treatment area was 80 mm × 120 mm, leaving approximately 4 cm untreated margin from the edge of the film. Plasma treatment was performed at sub-atmospheric pressure (1600 Pa) using an O2/Air mixture at a gas flow rate of 200 mL/min for O2 and 500 mL/min for air. The applied power was held at 84 W and the treatment time was 120 s. Following treatment, plasma treated samples were placed in ziplock plastic bags to protect films from antistatic environments and dust particles.

Figure 1.
(a) Illustration of cold plasma treatment of biaxially oriented polypropylene (BOPP) low density polyethylene (LDPE) films; atomic force microscopy (AFM) surface images and static water contact angle (SWCA) photos of BOPP/LDPE films (b) before and (c) after cold plasma treatment.
2.3. Preparation of NC/Nisin Coating Solution
A stock solution of nisin (1.5% w/w) was freshly prepared by dispersing 1.5 g of the nisin powder in 100 mL of hydrochloric acid (0.01 M) under magnetic stirring overnight. Then aliquots of the nisin solution were mixed with NC suspension under magnetic stirring for 3 h followed by homogenization with mechanical homogenizer (Unidrive-Model X1000D, CAT Scientific, Inc, Paso Robles, CA, USA) at 15,000 rpm for 10 min and kept overnight at 4 °C.
Various coating solutions of different NC/nisin ratio, named as NC/S1, NC/S3, and NC/S5, were prepared and the nisin content in each formulation was calculated to be 1 mg/g, 3 mg/g, and 5 mg/g, respectively, based on the amount of pure nisin per dry weight of coatings. NC in each coating formula was constant at 1.0% by weight of solid contents.
2.4. Surface Coating of BOPP/LDPE Film
The process for preparation of BOPP/LDPE active packaging is schematic represent in Figure 2a. In brief, wire-bar-coating process was used to deposit coating solution (neat NC or NC/nisin mixture) on plasma-treated BOPP/LDPE films of LDPE surface side, and subsequently the wet coating was dried overnight at room temperature under ambient conditions. On each BOPP/LDPE sample (120 mm × 160 mm), NC/nisin coatings were attached only on plasma-treated areas (80 mm × 120 mm) and the edges of each BOPP/LDPE films were clear of any coatings. In the coating process, a wire-bar applicator (K303, RK Print-Coat Instruments Ltd., Royston, UK) was used for preparing uniform films of coating on BOPP/LDPE substrates at a velocity of 3 m/min and the coating weight was controlled to approximately 3 g/m2 using rod #6.

Figure 2.
(a) Surface coating of nano-fibrillated cellulose (NC)/nisin onto BOPP/LDPE films for food packaging application; (b) SWCA of the coated film at different nisin contents.
2.5. Surface Wettability of the Films
The surface wettability of the samples was evaluated by static water contact angle (SWCA) measurement. All samples were conditioned and tested at 23 °C and 50% relative humidity (RH) prior to testing. The static contact angles of water droplets (3 μL) on the films were measured using drop shape analyzer (modelDSA100, KRÜSS Optronic GmbH, Hamburg, Germany) over a period of 10 s [35]. Ten measurements were recorded for each sample.
2.6. Microscope Observations of the Films
Atomic force microscopy (AFM) was used to monitor topographical changes to the LDPE surface during plasma treatment. Innovative scanning probe microscopy (SPM) with an AFM 5000IIcontroller (Hitachi High-Tech, Tokyo, Japan) in a tapping mode was used with a silicon probe (SI-DF40P2, f = 28 kHz, Hitachi High-Tech, Japan). The average roughness (Ra) and root-mean-squared roughness (Rq) were measured from the analysis of the images at a 2 μm × 2 μm scan size.
The surface and cross section of the films were characterized by scanning electron microscopy (SEM) on PhenomPro (Phenom-World, Eindhoven, The Netherlands) at 10 kV. The specimens were cryofractured by immersion freeze in liquid nitrogen prior to placing in the gold sputter-coater.
2.7. Optical Properties of the Films
The regular light transmittances of the films were measured at wavelengths from 200 to 1100 nm using an ultraviolet (UV)-visible spectrometer (SPECORD®50 PLUS, Analytic Jena AG, Jena, Germany) by triplicate.
2.8. Mechanical Properties of the Films
Tensile strength, tensile modulus, and elongation at break of the films were measured by using a universal testing machine (model 3367, Instron, Norwood, MA, USA) with a cross head speed of 100 mm/min, according to ASTM D882 [36]. The film was cut to size 150.0 mm × 15.0 mm and triple repeats were performed for each sample. The average film thickness was measured using a Digital Micrometer (model 49–56, Testing Machines, Inc., New Castle, DE, USA) at ten random positions on the film.
2.9. Gas Barrier Properties of the Films
All the samples together with the uncoated substrate materials used were characterized for their oxygen transmission rate (OTR) expressed as cc/m2·day and water vapor transmission rate (WVTR) expressed as g/m2·day. The OTR measurements were carried out using Mocon OXTRAN Model 2/21 equipment (MOCON Inc., Minneapolis, MN, USA) under a condition of room temperature (23 °C) and at 50% relative humidity. The WVTR measurements were carried out using Mocon PERMATRAN-W 3/61 (MOCON Inc., Minneapolis, MN, USA) at 23 °C and 75% relative humidity. The coating side of the sample faced the carrier gas stream and three parallel samples were measured in both OTR and WVTR test.
2.10. Antimicrobial Activity of the Films Against L. monocytogenes
The L. monocytogenes cultures were propagated through two consecutive 24 h growth periods in brain heart infusion (BHI) broth at 37 °C to obtain the working cultures containing approximately 108 CFU/mL. The quantitative inhibitory effect of the films was carried out by putting 0.10 g test sample scraps in 5 mL of L. monocytogenes cell suspension of 106 CFU/mL and shaken at 200 rpm in an incubator at 37 °C. After 60 min of contact time, the cultures were enumerated by plating onto BHI agar and incubating for 24 h at 37 °C. Thecolony forming units (CFU) of L. monocytogenes were determined and used to assess the antimicrobial activity of the films. The inhibition of the L. monocytogenes growth was calculated based on the following equation:
where A and B are the number of the colonies counted from the control and the corresponding film sample, respectively. Those experiments were made in triplicates and all the values were expressed as a mean value.
Growth inhibition rate (%) = (A − B)/A × 100%
2.11. Statistical Analysis
The Duncan’s multiple-range test was used to determine any significant difference between specific means at 95% confidence interval. The analysis was carried out using the SPSS for Windows (Version 22.0, SPSS Statistical software, Inc., Chicago, IL, USA) software package.
3. Results and Discussions
3.1. Hydrophilic Analysis of the Films
The hydrophilic behavior of the untreated and plasma treated BOPP/LDPE films were estimated by measuring static water contact angle of the LDPE side, which also provided information about the affinity between coating agents and LDPE. Figure 1b,c describes the change in surface topography and water wettability of BOPP/LDPE film before and after plasma treatment.
The SWCA of untreated BOPP/LDPE film was found to be 92.4° which means the surface of LDPE is hydrophobic. However, the value of SWCA decreased to 60.5° when the film was treated by O2/air plasmas. The decrease in SWCA after plasma treatment clearly indicates that the surface of the LDPE is transformed from hydrophobic to hydrophilic as compared with the untreated film. Several studies attribute the change in hydrophilicity to the generation of polar function groups on the surface of LDPE by oxygen plasma [16,37,38]. The change of surface chemistry before and after plasma treatment could also be revealed by AFM phase images as shown Figure 1b,c. Different degrees of phase lagging indicate a sample surface with different degrees of softness or vertical adhesion [39]. The change in the phase contrast is directly corresponding to wettability of the film surface. Since the surface of film is hydrophilic after plasma treatments, and the NC or NC/nisin in the coating agents are mainly hydrophilic, it is easy to observe a visible improved affinity between the wet coating and the plasma treated BOPP/LDPE films. It is worth noting that a good adhesion of the coating layer on the BOPP/LDPE film occurs only after the plasma treatment.
In addition to polar functional groups, plasma may also assist changes in surface morphology [37]. The untreated BOPP/LDPE film showed a low Ra of 7.32 nm indicating a relatively smooth surface and there was only a slight increase in surface roughness (Ra = 8.77) when the surface was treated by plasma. This suggests that little or no etching of the surface occurs under the condition used.
Accordingly, when a coating of neat NC was applied on the plasma treated film, a lower water contact angle of 43.6° was observed compared to the plasma treated film since an abundant of hydrophilic groups present on each individual NC surface. When both nisin and NC were incorporated in coating solutions and coated onto the plasma treated BOPP/LDPE film, the SWCA of BOPP/LDPE film after coating gradually goes down. The lowest contact angle value was observed for the film with coating NC/S5. The increase in nisin content is theoretically good for controlling the growth of micro-organisms but it probably accompanies a loss in water vapor barrier performance of the film to the contrary. This is because the low water contact angle value indicates that the coating layer has a good affinity with water, which is related to an insufficient water vapor barrier [40].
3.2. Mechanical Properties
Films intended for packaging need adequate mechanical performance. Tensile strength is related to the mechanical strength of films, whereas the tensile modulus and elongation at break is related to the rigidity and flexibility of the films, respectively [34]. Table 1 compares the mechanical properties of BOPP/LDPE films under different surface process.

Table 1.
Mechanical properties of BOPP/LDPE films under different surface process.
The value of tensile strength and tensile modulus obtained for plasma treated film is slightly lower than the untreated film, which is reasonable since plasma etching effect performs only a few nanometers depths without changing bulk properties of the film. It is also interesting to note that both the tensile strength and modulus of the films after coating display a slight decrease with nisin concentration, which is reasonable considering that higher concentrations of nisin give rise to higher heterogeneity of the coating layer, thus having a lower resistance toward deformation. However, the change in tensile strength, tensile modulus and elongation at break was believed non-significant (p > 0.05) because the calculated significance level of the test was 0.705, 0.481 and 0.360, respectively. Interestingly, even though a strong adhesion between BOPP/LDPE substrate and the NC or NC/nisin coating layer was observed during tensile test, the NC or NC/nisin coating did not improve mechanical properties of the film as expected. In fact, owing to the strong interaction between nanofibrils during drying, NFC was reported to form very strong films with excellent dry and wet strength [41]. However, the thickness of the coating layer in this test was less than 3 μm, and thus, there was not sufficient NC to form a strong nanofibrillar network structure and improve mechanical performance of the films [42]. In this state, the coatings do not influence the mechanical properties of BOPP/LDPE films to any extent that hinders its physical integrity in packaging applications.
3.3. Optical Properties
Figure 3 compares the light transmittance spectra of BOPP/LDPE films under different surface process. The untreated film is practically transparent with a transmittance of 86.33% at 600 nm (center of visible light spectrum). A similar transmittance of 85.20% was observed for the plasma treated film, revealing that the plasma treatment did not visibly change the transparency of BOPP/LDPE film. In addition, there was no obvious difference in the thickness of film before and after plasma treatment. However, the film was less transparent after NC coating and the transmittance at 600 nm was reduced to 71.86%, which may be explained by the size effect and aggregates of NC fibrils [43,44]. As the nisin concentration in the coating increased from 1 mg/g to 5 mg/g, the light transmittance of BOPP/LDPE film decreased from 70.74% to 66.04%. The decreased transmittance could be due to the deposition of salt crystals (present in nisin) as well as nisin granules on the surface of the films [34]. It is noteworthy that all BOPP/LDPE films exhibit satisfying transparency (>66.04%) ideal for products display.

Figure 3.
Light transmission of BOPP/LDPE films under different surface process.
3.4. Barrier Properties
Water vapor and oxygen resistivity are fundamental requirement for packaging materials since both of them may trigger several food changes such as nutrient deterioration and microbial growth, which finally influence the shelf life of the packaged products [45]. Accordingly, all films were subjected to water vapor barrier and oxygen barrier testing. Results are summarized in Figure 4. Obviously, the OTR of coated BOPP/LDPE films is decreased compared with uncoated BOPP/LDPE, but the WVTR of coated BOPP/LDPE films do not show any significant deviations from those of uncoated BOPP/LDPE.

Figure 4.
Oxygen transmission rate and water vapor transmission rate of BOPP/LDPE films under different surface process.
A high oxygen barrier is an essential property for food packaging. A packaging material is considered to be a good oxygen barrier if the OTR is approximately 1–10 cc/m2·day [46]. OTR values of packaging films prepared from commercial polyethylene terephthalate (PET) and polyethylene terephthalate/polyethylene (PET/PE) have been reported around 110 cc/m2·day and 1.24 cc/m2·day, respectively [47]. In this study, the average OTR for BOPP/LDPE films without any treatment was 67.03 cc/m2·day which was similar to the film with plasma treatment (65.03 cc/m2·day). Compared with uncoated BOPP/LDPE, NC coatings decrease the OTR significantly. Typically, BOPP/LDPE films with a NC coating display lowest OTR (24.02 cc/m2·day). NC films are known to be good oxygen barriers and this can be explained by the “tortuous path” mechanism [48]. The high entanglements of NC fibrils plus the abundance of hydrogen bonding form a dense structures within the NC films, and this lead to a tortuous diffusion path for the penetration of oxygen molecules [8]. Accordingly, NC coatings dramatically decrease the OTR of BOPP/LDPE backing compared with uncoated BOPP/LDPE films. Similar OTR values of 17.8 cc/m2·day have been reported with pure NC films and this is believed to satisfy the OTR requirement for most practical packaging applications [49].
However, when nisin is used as the cocomponent in the coating, the average OTR gradually increased at increasing amounts of nisin in the films. Increased permeability to oxygen may be attributed to the discontinuation of the coating layer at higher nisin concentrations. When nisin is used as the cocomponent, homogeneity of the NC film is impaired by the high concentration of nisin and thus yields heterogeneous films. The homogeneity and topography of produced films were more closely observed by SEM. Representative images are shown in Figure 5. The untreated BOPP/LDPE film displays a bilayer structure, a thin BOPP layer attached on a thick LDPE layer with a homogeneous and smooth surface. In fact, the BOPP layer was easily peeled from the LDPE layer due to the cryofracture force and only LDPE layers were visible in most SEM images. After plasma treatment, no visible changes were observed on LDPE surface. But after coating, an additional layer of 3–4 μm thick was observable on the surface of LDPE. Furthermore, by the addition of nisin to NC, the coating layer tends to lose its evenness and strength because more visible cracks appeared on the coating layer. When the concentration of nisin increased, traces of insoluble nisin were observed on the coating surface, particularly on the film with NC/S5 coating. Concerning SEM analysis and OTR values as mentioned above, it seems that at the higher amount of nisin in the coating, insoluble nisin would be harm to the uniformity of the NC matrix structure, facilitating oxygen permeation through the composite film, and subsequently hazarding the barrier properties of the films.

Figure 5.
SEM images of BOPP/LDPE films under different surface process.
WVTR of film is another key value worth considering in barrier packaging. It was revealed that changes in water vapor barrier properties for the BOPP/LDPE films were less significant compared to the changes in oxygen permeability. As shown in Figure 4, the WVTR of coated BOPP/LDPE films do not show any significant deviations (p = 0.299 > 0.05) from those of uncoated BOPP/LDPE. Similarly, changes in concentration of nisin do not have much significant influence on WVTR, fluctuating around an average level of 4.05. It is suggested that the NC coating or NC/nisin coating show a limited water vapor barrier performance, and this could be attributed to the hydrophilic OH groups in the nanofibrillated cellulose.
3.5. Antimicrobial Activity
In this study, nisin is used as antimicrobials in packaging to enhance food safety by reducing the growth rate and maximum population of microorganisms (spoilage and pathogenic) [50]. In Figure 6, the effect of coating treatment on antimicrobial activity properties of BOPP/LDPE films is shown.
Figure 6.
(a) Antimicrobial activity assay and (b) growth inhibition rate of BOPP/LDPE films against L. monocytogenes.
The observed results indicate that untreated BOPP/LDPE films or NC coated BOPP/LDPE films barely show any inhibition against L. monocytogenes. In contrast, the addition of nisin cocomponents improves the antimicrobial properties of films as anticipated. Moreover, the higher the relative amount of nisin, the higher growth inhibition rate. It is well established that nisin can effectively control L. monocytogenes in foods by initiating pore formation in the cell membrane and hindering cell wall synthesis [51]. As a result, increasing the nisin concentration to 5 mg/g resulted in a significant reduction (p < 0.05) in L. monocytogenes counts in comparison to the control.
In fact, combining NC with nisin in the coating on BOPP/LDPE film may provide several advantages in food packaging applications. First, imbedding of nisin in the NC matrix possibly result in a sustained release of nisin due to the reduction of free nisin available for diffusion, thus allowing for a long-term antimicrobial activity and extended shelf-life [52,53]. Secondly, the NC layer could work as a biocompatible barrier against some possible migrations of hazard chemical compounds from BOPP/LDPE film to the food matrix during storage [54]. In addition, each coated BOPP/LDPE film still reserve its heat-sealing merit because the NC/nisin coatings attached only on the plasma treated areas, leaving untreated margin from the edge of the film available for heat-sealing to form a pouch. Overall, the incorporation of nisin in NC coatings onto the BOPP/LDPE films show promise in the control of L. monocytogenes and could potentially serve as a novel antimicrobial technique for application onto conventional plastic food packaging materials.
4. Conclusions
A new type of active packaging with antimicrobial and enhanced oxygen barrier properties was prepared by surface coating of NC/nisin mixture onto BOPP/LDPE film. Cold plasma treatment improved the surface hydrophilicity of BOPP/LDPE films and enhanced their affinity for the coating. Compared with uncoated BOPP/LDPE, NC coatings decrease the OTR value significantly, as low as 24.02 cc/m2·day. After the addition of nisin to NC, the coating layer tends to lose its uniformity and subsequently hazarding the oxygen barrier performance of the coated films concerning SEM analysis and OTR values. In contrast, changes in concentration of nisin do not have much significant influence on WVTR. Nevertheless, the growth of L. monocytogenes on the BOPP/LDPE film was significantly reduced with the increase of the nisin concentration in the coating. Additionally, all BOPP/LDPE films exhibited satisfying mechanical properties and transparency based on investigations of mechanical properties and light transmittance spectra. It is suggested that NC/nisin coatings could impart antimicrobial functions on commercial packaging films and have potential as an alternative to existing synthetic oxygen-barrier polymers in composite structures for food packaging applications.
Author Contributions
P.L. and M.W. conceived and designed the experiments; M.G. and Z.X. performed the experiments; P.L. and M.W. analyzed the data; M.G. contributed reagents/materials/analysis tools; P.L. wrote the manuscript and M.W. edited the manuscript.
Funding
This research was funded by the National Natural Science Foundation of China (Grant No. 21706041), State Key Laboratory of Pulp and Paper Engineering (201737), Dean Project of Guangxi Key Laboratory of Clean Pulp & Papermaking and Pollution Control (ZR201604 & ZR201708), Foundation of Key Laboratory of Pulp and Paper Science and Technology of Ministry of Education/Shandong Province of China (No. KF201617), and the Scientific Research Foundation of Guangxi University (Grant No. XGZ160294).
Conflicts of Interest
The authors declare no conflict of interest. The founding sponsors had no role in the design of the study; in the collection, analyses, or interpretation of data; in the writing of the manuscript, and in the decision to publish the results.
References
- Moon, R.J.; Martini, A.; Nairn, J.; Simonsen, J.; Youngblood, J. Cellulose nanomaterials review: structure, properties and nanocomposites. Chem. Soc. Rev. 2011, 40, 3941–3994. [Google Scholar] [CrossRef] [PubMed]
- López-Rubio, A.; Lagaron, J.M.; Ankerfors, M.; Lindstrőm, T.; Nordqvist, D.; Mattozzi, A.; Hedenqvist, M.S. Enhanced film forming and film properties of amylopectin using micro-fibrillated cellulose. Carbohyr. Polym. 2007, 68, 718–727. [Google Scholar] [CrossRef]
- Rodionova, G.; Lenes, M.; Eriksen, Ø.; Gregerse, Ø. Surface chemical modification of microfibrillated cellulose: Improvement of barrier propertiesfor packaging applications. Cellulose 2011, 18, 127–134. [Google Scholar] [CrossRef]
- Herrera, M.A.; Mathew, A.P.; Oksman, K. Barrier and mechanical properties of plasticized and cross-linked nanocellulose coatings for paper packaging applications. Cellulose 2017, 24, 3969–3980. [Google Scholar] [CrossRef]
- Lavoine, N.; Desloges, I.; Sillard, C.; Bras, J. Controlled release and long-term antibacterial activity of chlorhexidine digluconate through the nanoporous network of microfibrillated cellulose. Cellulose 2014, 21, 4429–4442. [Google Scholar] [CrossRef]
- Ferrer, A.; Pal, L.; Hubbe, M. Nanocellulose in packaging: Advances in barrier layer technologies. Ind. Crops Prod. 2017, 95, 574–582. [Google Scholar] [CrossRef]
- Fang, Z.; Zhao, Y.; Warner, R.D.; Johnson, S.K. Active and intelligent packaging in meat industry. Trends Food Sci. Technol. 2017, 61, 60–71. [Google Scholar] [CrossRef]
- Syverud, K.; Stenius, P. Strength and barrier properties of MFC films. Cellulose 2009, 16, 75–85. [Google Scholar] [CrossRef]
- Lange, J.; Wyser, Y. Recent innovations in barrier technologies for plastic packaging—A review. Packag. Technol. Sci. 2003, 16, 149–158. [Google Scholar] [CrossRef]
- Hong, S.-I.; Krochta, J.M. Oxygen barrier properties of whey protein isolate coatings on polypropylene films. J. Food Sci. 2010, 68, 224–228. [Google Scholar] [CrossRef]
- Tihminlioglu, F.; Atik, İ.D.; Őzen, B. Water vapor and oxygen-barrier performance of corn-zein coated polypropylene films. J. Food Eng. 2010, 96, 342–347. [Google Scholar] [CrossRef]
- Herrera, M.A.; Sirviö, J.; Mathew, A.P.; Oksman, K. Environmental friendly and sustainable gas barrier on porous materials: Nanocellulose coatings prepared using spin- and dip-coating. Mater. Design. 2016, 93, 19–25. [Google Scholar] [CrossRef]
- Pandiyaraj, K.N.; Kumar, A.A.; Ramkumar, M.C.; Deshmukh, R.R.; Bendavid, A.; Su, P.-G.; Kumar, U.; Packirisamy, G. Effect of cold atmospheric pressure plasma gas composition on the surface and cyto-compatible properties of low density polyethylene (LDPE) films. Curr. Appl. Phys. 2016, 16, 784–792. [Google Scholar] [CrossRef]
- Misra, N.N.; Jo, C. Applications of cold plasma technology for microbiological safety in meat industry. Trends Food Sci. Technol. 2017, 64, 74–86. [Google Scholar] [CrossRef]
- Tendero, C.; Tixier, C.; Tristant, P.; Desmaison, J.; Leprince, P. Atmospheric pressure plasmas: A review. Spectrochim. Acta Part B At. Spectrosc. 2006, 61, 2–30. [Google Scholar] [CrossRef]
- Pandiyaraj, K.N.; Deshmukh, R.R.; Ruzybayev, I.; Shah, S.I.; Su, P.-G.; Halleluyah, J.M.; Halim, A.S. Influence of non-thermal plasma forming gases on improvement of surface properties of low density polyethylene (LDPE). Appl. Surf. Sci. 2014, 307, 109–119. [Google Scholar] [CrossRef]
- Clarke, D.; Tyuftin, A.A.; Cruzromero, M.C.; Bolton, D.; Fanning, S.; Pankaj, S.K.; Bueno-Ferrer, C.; Cullen, P.J.; Kerry, J.P. Surface attachment of active antimicrobial coatings onto conventional plastic-based laminates and performance assessment of these materials on the storage life of vacuum packaged beef sub-primals. Food Microbiol. 2017, 62, 196–201. [Google Scholar] [CrossRef] [PubMed]
- Ozen, B.F.; Floros, J.D. Effects of emerging food processing techniques on the packaging materials. Trends Food Sci. Technol. 2001, 12, 60–67. [Google Scholar] [CrossRef]
- Hong, S.-I.; Krochta, J.M. Whey protein isolate coating on LDPE film as a novel oxygen barrier in the composite structure. Packag. Technol. Sci. 2004, 17, 13–21. [Google Scholar] [CrossRef]
- Shukri, N.A.; Ghazali, Z.; Fatimah, N.A.; Mohamad, S.F.; Wahit, M.U. Physical, mechanical and oxygen barrier properties of antimicrobial active packaging based on ldpe film incorporated with sorbic acid. Adv. Environ. Biol. 2014, 8, 2748–2752. [Google Scholar]
- Störmer, A.; Bott, J.; Kemmer, D.; Franz, R. Critical review of the migration potential of nanoparticles in food contact plastics. Trends Food Sci. Technol. 2017, 63, 39–50. [Google Scholar] [CrossRef]
- Ribeiro-Santos, R.; Andrade, M.; Melo, N.R.D.; Sanches-Silva, A. Use of essential oils in active food packaging: Recent advances and future trends. Trends Food Sci. Technol. 2017, 61, 132–140. [Google Scholar] [CrossRef]
- Limjaroen, P.; Ryser, E.T.; Lockhart, H.; Harte, B. Development of a food packaging coating material with antimicrobial properties. J. Plast. Film Sheet. 2003, 19, 95–109. [Google Scholar] [CrossRef]
- Lopes, N.A.; Pinilla, C.M.B.; Brandelli, A. Pectin and polygalacturonic acid-coated liposomes as novel delivery system for nisin: Preparation, characterization and release behavior. Food Hydrocoll. 2017, 70, 1–7. [Google Scholar] [CrossRef]
- Benech, R.O.; Kheadr, E.E.; Laridi, R.; Lacroix, C.; Fliss, I. Inhibition of Listeria innocua in cheddar cheese by addition of nisin Z in liposomes or by in situ production in mixed culture. Appl. Environ. Microb. 2002, 68, 3683–3690. [Google Scholar] [CrossRef]
- Janes, M.E.; Kooshesh, S.; Johnson, M.G. Control of Listeria monocytogenes on the surface of refrigerated, ready-to-eat chicken coated with edible zein film coatings containing nisin and/or calcium propionate. J. Food Sci. 2002, 67, 2754–2757. [Google Scholar] [CrossRef]
- Cui, H.; Wu, J.; Li, C.; Lin, L. Improving anti-Listeria activity of cheese packaging via nanofiber containing nisin-loaded nanoparticles. LWT-Food Sci. Technol. 2017, 81, 233–242. [Google Scholar] [CrossRef]
- Cutter, C.N.; Willett, J.L.; Siragusa, G.R. Improved antimicrobial activity of nisin-incorporated polymer films by formulation change and addition of food grade chelator. Lett. Appl. Microbiol. 2001, 33, 325–328. [Google Scholar] [CrossRef] [PubMed]
- Zhu, X.; Loh, X.J. Layer-by-layer assemblies for antibacterial applications. Biomater. Sci. 2015, 3, 1505–1518. [Google Scholar] [CrossRef] [PubMed]
- Salmieri, S.; Islam, F.; Khan, R.A.; Hossain, F.M.; Ibrahim, H.M.M.; Miao, C.; Hamad, W.Y.; Lacroix, M. Antimicrobial nanocomposite films made of poly(lactic acid)-cellulose nanocrystals (PLA-CNC) in food applications: Part A—Effect of nisin release on the inactivation of Listeria monocytogenes in ham. Cellulose 2014, 21, 1837–1850. [Google Scholar] [CrossRef]
- Khan, A.; Gallah, H.; Riedl, B.; Bouchard, J.; Safrany, A.; Lacroix, M. Genipin cross-linked antimicrobial nanocomposite films and gamma irradiation to prevent the surface growth of bacteria in fresh meats. Innov. Food Sci. Emerg. 2016, 35, 96–102. [Google Scholar] [CrossRef]
- Aveyard, J.; Bradley, J.W.; Mckay, K.; McBride, F.; Donaghy, D.; Raval, R.; D’Sa, R.A. Linker-free covalent immobilization of nisin using atmospheric pressure plasma induced grafting. J. Mater. Chem. B 2017, 5, 2500–2510. [Google Scholar] [CrossRef]
- Duday, D.; Vreuls, C.; Moreno, M.; Frache, G.; Boscher, N.D.; Zocchi, G.; Archambeau, C.; Weerdt, C.V.D.; Martial, J.; Choquet, P. Atmospheric pressure plasma modified surfaces for immobilization of antimicrobial nisin peptides. Surf. Coat. Technol. 2013, 218, 152–161. [Google Scholar] [CrossRef]
- Khan, A.; Salmieri, S.P.; Fraschini, C.; Bouchard, J.; Riedl, B.; Lacroix, M. Genipin cross-linked nanocomposite films for the immobilization of antimicrobial agent. ACS Appl. Mater. Interfaces 2014, 6, 15232–15242. [Google Scholar] [CrossRef] [PubMed]
- Yu, M.; Wang, Z.; Liu, H.; Xie, S.; Wu, J.; Jiang, H.; Zhang, J.; Li, L.; Li, J. Laundering durability of photocatalyzed self-cleaning cotton fabricwith TiO2 nanoparticles covalently immobilized. ACS Appl. Mater. Interfaces 2013, 5, 3697–3703. [Google Scholar] [CrossRef] [PubMed]
- ASTM. ASTM D882. In Standard Test Method for Tensile Properties of Thin Plastic Sheeting; ASTM International: West Conshohocken, PA, USA, 2009. [Google Scholar]
- Karam, L.; Jama, C.; Mamede, A.-S.; Fahs, A.; Louarn, G.; Dhulster, P.; Chihib, N.-E. Study of nisin adsorption on plasma-treated polymer surfaces for setting up materials with antibaterial properties. React. Funct. Polym. 2013, 73, 1473–1479. [Google Scholar] [CrossRef]
- Karam, L.; Jama, C.; Nuns, N.; Mamede, A.-S.; Dhulster, P.; Chihib, N.-E. Nisin adsorption on hydrophilic and hydrophobic surfaces: Evidences of its interactions and antibacterial activity. J. Pept. Sci. 2013, 19, 377–385. [Google Scholar] [CrossRef] [PubMed]
- Park, H.; Xu, S.; Seetharaman, K. A novel in situ atomic force microscopy imaging technique to probe surface morphological features of starch granules. Carbohyr. Res. 2011, 346, 847–853. [Google Scholar] [CrossRef] [PubMed]
- Lu, P.; Zhang, W.; He, M.; Yan, Y.; Xiao, H. Cellulase-assisted refining of bleached softwood kraft pulp for making water vapor barrier and grease-resistant paper. Cellulose 2016, 23, 891–900. [Google Scholar] [CrossRef]
- Österberg, M.; Vartiainen, J.; Lucenius, J.; Hippi, U.; Seppälä, J.; Serimaa, R.; Laine, J. A fast method to produce strong NFC films as a platform for barrier and functional materials. ACS Appl. Mater. Interface 2013, 5, 4640–4647. [Google Scholar] [CrossRef] [PubMed]
- Henriksson, M.; Berglund, L.A.; Isaksson, P.; Lindstrőm, T.; Nishino, T. Cellulose nanopaper structures of high toughness. Biomacromolecules 2008, 9, 1579–1585. [Google Scholar] [CrossRef] [PubMed]
- Fukuzumi, H.; Saito, T.; Iwata, T.; Kumamoto, Y.; Isogai, A. Transparent and high gas barrier films of cellulose nanofibers prepared by TEMPO-mediated oxidation. Biomacromolecules 2009, 10, 162–165. [Google Scholar] [CrossRef] [PubMed]
- Aulin, C.; Gällstedt, M.; Lindström, T. Oxygen and oil barrier properties of microfibrillated cellulose films and coatings. Cellulose 2010, 17, 559–574. [Google Scholar] [CrossRef]
- Soni, B.; Hassan, E.B.; Schilling, M.W.; Mahmoud, B. Transparent bionanocomposite films based on chitosan and TEMPO-oxidized cellulose nanofibers with enhanced mechanical and barrier properties. Carbohyr. Polym. 2016, 151, 779–789. [Google Scholar] [CrossRef] [PubMed]
- Abdellatief, A.; Welt, B.A. Comparison of new dynamic accumulation method for measuring oxygen transmission rate of packaging against the steady-state method described by ASTM D3985. Packag. Technol. Sci. 2013, 26, 281–288. [Google Scholar] [CrossRef]
- Brody, A.L.; Bugusu, B.; Han, J.H.; Sand, C.K.; Mchugh, T.H. Innovative food packaging solutions. J. Food Sci. 2008, 73, R107–R116. [Google Scholar] [CrossRef] [PubMed]
- Belbekhouche, S.; Bras, J.; Siqueira, G.; Chappey, C.; Lebrun, L.; Khelifi, B.; Marais, S.; Dufresne, A. Water sorption behavior and gas barrier properties of cellulose whiskers and microfibrils films. Carbohyr. Polym. 2011, 83, 1740–1748. [Google Scholar] [CrossRef]
- Rastogi, V.K.; Samyn, P. Bio-based coatings for paper applications. Coatings 2015, 5, 887–930. [Google Scholar] [CrossRef]
- Quintavalla, S.; Vicini, L. Antimicrobial food packaging in meat industry. Meat Sci. 2002, 62, 373–380. [Google Scholar] [CrossRef]
- Wu, S.; Yu, P.-L.; Flint, S. Persister cell formation of Listeria monocytogenes in response to natural antimicrobial agent nisin. Food Control 2017, 77, 243–250. [Google Scholar] [CrossRef]
- Luchansky, J.B.; Call, J.E. Evaluation of nisin-coated cellulose casings for the control of Listeria monocytogenes inoculated onto the surface of commercially prepared frankfurters. J. Food Prot. 2004, 67, 1017–1021. [Google Scholar] [CrossRef] [PubMed]
- Balasubramanian, A.; Lee, D.S.; Chikindas, M.L.; Yam, K.L. Effect of Nisin’s controlled release on microbial growth as modeled for micrococcus luteus. Probiotics Antimicrob. 2011, 3, 113–118. [Google Scholar] [CrossRef] [PubMed]
- Honarvar, Z.; Farhoodi, M.; Khani, M.R.; Mohammadi, A.; Shokri, B.; Ferdowsi, R.; Shojaee-Aliabadi, S. Application of cold plasma to develop carboxymethyl cellulose-coated polypropylene films containing essential oil. Carbohyr. Polym. 2017, 176, 1–10. [Google Scholar] [CrossRef] [PubMed]
© 2018 by the authors. Licensee MDPI, Basel, Switzerland. This article is an open access article distributed under the terms and conditions of the Creative Commons Attribution (CC BY) license (http://creativecommons.org/licenses/by/4.0/).